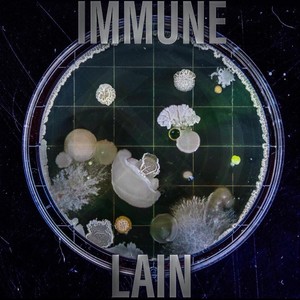
Immune

当前位置:首页 >> Lain >> 歌曲列表 第页
Lain
此歌手暂无简介
热门歌曲
更多..
-
-
-
Barloe Team、KayCyy、Lain 3.71 MB 04:03
-
-
-
Lain 2.6 MB 02:50
-
-
-
-
-
-
-
-
-
Lain 3.21 MB 03:30
-
Lain、Michelle Ortiz 2.88 MB 03:08
-
Lain 4.25 MB 04:38
-
Angie Stone、Lain 3.93 MB 04:17
-
-
Christofe、Lain、Federico Liberatore 2.54 MB 02:46
-
-
-